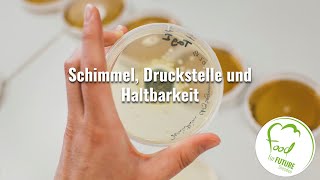

Thomas Dürmeier | Fusion Bayer und Monsanto
Dieses Referat wurde im Rahmen der Veranstaltung von MultiWatch Basel und Denknetz am 19.12.2017 in Basel gehalten. Thema: Die Mega-Fusionen der ...
Denknetz
Rückstände in Obst und Gemüse -- Verbrauchersorgen ohne Grund
Viele Verbraucher sorgen sich ohne Grund um Rückstände von Pflanzenschutzmitteln in landwirtschaftlichen Produkten. Tatsächlich hat sich die Situation in ...
Presseportal Videos
Data Science by INFORM Teil 1: Machine Learning Grundlagen und Anwendungsfälle
In diesem Webinar erfahren Sie, was sich konkret hinter dem Hype Machine Learning verbirgt. Entdecken Sie anhand von Praxisbeispielen aus verschiedenen ...
INFORM GmbH
Cannabis NEWS November 2020 - Mazedonien, Argentinien, Mexico, EU, München, Schweiz, Österreich
Mazedonien plant Legalisierung Der mazedonische Premierminister Zoran Zaev kündigte einen Plan zur Regulierung des legalen Cannabismarktes im Land ...
CIA-TV
Bayer AG Aktie - Aktienanalyse - vor Glyphosat-Urteil noch günstig kaufen?
Ist dei Bayer AG noch einen Kauf vor dem Glyphosat-Urteil wert? Im heutigen Video gehe ich unter anderem auf die aktuellen Finanzen aus dem 2. Quartal ...
Aktienwelt
24-Girl Anna (21) aus Mühldorf
12.10.2015 - Video von unserem 24-Girl Anna (21) aus Mühldorf (Copyright: TimeBreak21). Weitere Fotos findet ihr auf: ...
Innsalzach24
Urs Gfeller - der Gemüseproduzent ganz nah am Kunden
Urs Gfeller - le producteur de légumes tout proche du client Urs Gfeller – l'orticoltore vicino al cliente.
biosuisse
Klima-Diskussion aus geowissenschaftlicher Sicht - keb Heilbronn
Vortragsreihe der keb Heilbronn „Orte entdecken-Denkräume gestalten“ mit Professor Dr. Ulrich Glasmacher, Institut für Geowissenschaften, Universität ...
keb Heilbronn
Dr Rath EU: perspectives politiques
Ce que vous aviez toujours voulu savoir sur "l'Union Européenne de Bruxelles" -- Mais que personne n'osait vous dire ! http://www.relay-of-life.org/fr/index.html ...
RathFoundation
Prof.Dr. J. Berghold: Hindernisse gegen ein Ernstnehmen der Klimakatastrophe
Prof.Dr. J. Berghold, attac Lübeck, Universität Lüneburg, Mitglied im wiss. Beirat von attac Die führenden Klimawissenschaftler/innen der Welt läuten die ...
attac Lübeck
KLIMARAT BESORGT: Warnung vor Eisschmelze und Anstieg des Meeresspiegels
Angesichts immer stärker schmelzender Gletscher und anderer Eismassen mahnen Wissenschaftler die Politik zum raschen Handeln. Nur so könnten ...
WELT Nachrichtensender
Teil 1/2: Zwischen Zorn und Zärtlichkeit -- Die Geschichte des Biolandbaus in der Schweiz (2012)
00:00 Einleitung 01:28 1920 Mina Hofstetter - Mit der Reformbewegung zurück zur Natur 04:19 1920 Biologisch-dynamischer Landbau - Der Hof als ...
FiBLFilm
FluoriD ist nicht gleich FluoriT | Ist Fluorid giftig? | KARIESPROPHYLAXE | Schüssler-Salz Nr.1
Fluorid ist giftig sagen die einen - alles Quatsch, sagen die anderen. Ich wollte es genau wissen und habe recherchiert. Da ich Calciumfluorid schon lange als ...
Kerngesund-sein
Der Diskurs über die Gentechnik
Öffentliche Vorlesungsreihe: Wissenszukunft - Zukunftswissen ; Prof. Dr. Peter-Tobias Stoll (Göttingen), Der Diskurs über die Gentechnik,14. Mai 2009.
Universität Göttingen
3M Aktie, mehr als Filter und Post-Its
In diesem Video stelle ich dir 3M vor und was es zu einem Investmentkanditaten für dein Depot macht. Depot eröffnen ▻ Aktienhandel bei Trade Republic für ...
Finanzen kann jeder - Dividenden, P2P, Immobilien
Der WWF am Pranger - World Wildlife Fund als Werkzeug der Industrie (31.Aug.2011)
Der WWF gerät für seinen wirtschaftsnahen Kurs ins Kreuzfeuer der Kritik. Die wohl einflussreichste Umweltschutzorganisation der Welt verhelfe zweifelhaften ...
VeganCentury.com
Nahrungsergänzungsmittel - Teil 1/2
http://www.Whisky.de/shop/ Link zu Teil 2: http://youtu.be/nG_MPWzv4t8 Unsere Apotheken sind voll von freien Medikamenten und Nahrungsergänzungen.
Horst Lüning
Bayer - Risiko oder Chance? Die Aktienanalyse - Modern Value Investing
Heute sprechen wir über die Bayer Aktie. Die Bayer Aktienanalyse gibt es als Video aber auch als Artikel in Form einer ausführlichen Bayer Aktienanalyse.
Modern Value Investing
Historisches Museum Basel – Jahresmedienkonferenz 2018
museum #historischesmuseum #basel.
Historisches Museum Basel
Podiumsdiskussion: Volksbegehren „Rettet die Bienen“
Zum Schutz der Bienen soll der Einsatz von Pestiziden in den nächsten sechs Jahren halbiert werden. Pflanzenschutzmittel, die die Artenvielfalt gefährden, ...
badischezeitung
Investieren in Aktien wie Disney, Paypal, BASF & Co.. | Aktiv vs. Passiv | Finanzrocker Interview #1
ℹ️ Weitere Infos zum Video: Wir haben uns im Rahmen des Comdirect Finanzblog-Awards mit einem der bekanntesten Finanzblogger im deutschsprachigem ...
Finanzfluss
Food for Future | 6. Vortrag: Schimmel, Druckstellen und Haltbarkeit - kann ich das noch essen?
Wir sprechen über das MHD (Mindesthaltbarkeitsdatum), Schimmel und andere Beeinträchtigungen der Nahrung (eingedellte Dose) ob und wann man die noch ...
BUND Sachsen e.V.
Fuchs Petrolub Aktienanalyse – Ist die Aktie ein Kauf?
Fuchs Petrolub ist eines der deutschen Vorzeigeunternehmen und Weltmarktführer in seinem Bereich. Über Jahre hinweg stiegen Unternehmensgewinn, ...
Aktienfinder
Prof. Dr. Helmut Alt: Energiewende zwischen Wunsch und Wirklichkeit (IKEK-11)
Prof. Dr. Helmut Alt FH Aachen Energiewende zwischen Wunsch und Wirklichkeit Professor Alt erklärt in seinem Vortrag, wie es überhaupt zu einer solch ...
EIKE - Europäisches Institut für Klima und Energie
The Andersons & Patterson - Aktientip USA - spekulatives Trading, Aktientipps, Investment, Dividende
The Andersons & Patterson - Aktientip USA - spekulatives Trading - Aktientipps, Investment, Dividende. Bei de Unternehmen haben einen spannenden ...
Geduldtrader - Aktientipps, Trading & Börsenwissen